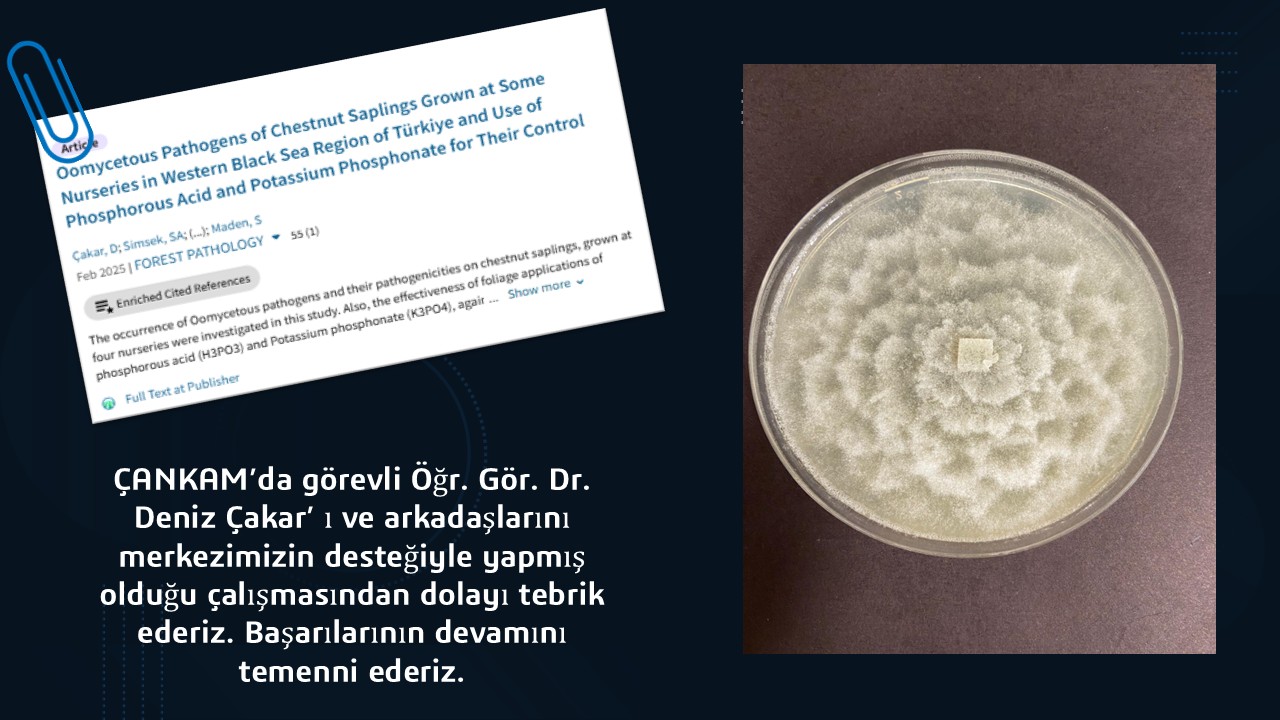

ÇANKIRI KARATEKİN ÜNİVERSİTESİ
Merkezi Araştırma Laboratuvarı Uygulama ve Araştırma Merkezi
ÇANKIRI KARATEKİN ÜNİVERSİTESİ
Merkezi Araştırma Laboratuvarı Uygulama ve Araştırma Merkezi
Hakkımızda
Personel
Analiz İşlemleri
Laboratuvarlar & Cihazlar
Referanslarımız
İletişim
Spektroskopi Laboratuvarı
Sıvı Nükleer Manyetik Rezonans (NMR) Spektroskopisi
İndüktif Eşleşmiş Plazma Kütle (ICP-MS) Spektroskopisi
Atomik Absorbsiyon Spektroskopisi (AAS)
Fourier Dönüşümlü Kızıl Ötesi (FTIR) Spektroskopisi
CHN/S Organik Element Analizörü
Toplam Organik Karbon (TOC) Spektroskopisi
UV-Vis Spektrofotometresi
Mikroplaka Okuyucu Spektrofotometre (ELISA Reader)
Mikroskopi Laboratuvarı
Malzeme Karakterizasyon Laboratuvarı
Malzeme Hazırlık Laboratuvarı
Termal Analiz Laboratuvarı
Kromatografi Laboratuvarı
Biyokimya Laboratuvarı
Diğer & Yardımcı Cihazlarımız